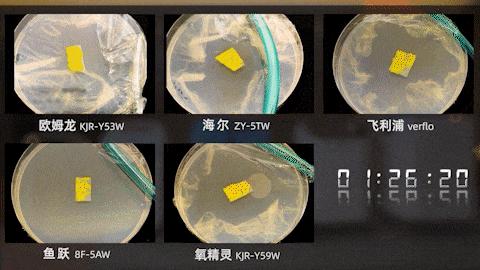
目前最好的制氧机有什么牌子,制氧机十大品牌评测

稿源:中关村在线
随着人们健康意识和疾病管理意识的增强,家用智能医疗产品越来越多的走入寻常百姓家,家用制氧机就是其中之一。一台制氧机,对呼吸系统疾病患者以及慢性病患者都有一定助益。
然而,面对市面上种类繁多、品牌五花八门、质量参差不齐的制氧机产品,选择一款可靠又适合自己的制氧机并非易事。所以这次我们选择了五款热度、口碑、销量都很高的主流家用制氧机。

在模拟的家庭使用环境与科学实验台前我们将对五款制氧机做出10个解剖式实验。通过实验,我们将充分展现每台制氧机的综合用料、使用体验、性能与优缺点,文章结尾我们将选出最具性价比的机型。
01 使用便捷度测试
制氧机的目标用户中有相当一部分为中老年人、孕妇、病患等特殊人群,所以机器是否操作简单易上手至关重要。首先进行对比的便是每台制氧机的外观设计,我们将从移动便捷度、操作逻辑合理性与外观三方面进行比对。
我们在陈设好的家庭环境中选取A、B两点,(A点在客厅一段、B点为沙发旁),模拟在家中推动设备 从客厅到沙发旁落座并使用的情况。

从实验结果来看,海尔ZY-5TW制氧机与飞利浦everflo制氧机的便捷度表现相对出色,海尔这款制氧机造型比较修长,整机高度十分适合推拉运动。唯一美中不足的是万向轮稍小。飞利浦制氧机虽然体积较大,但把手高度合理重量较轻,推拉发力顺畅。鱼跃制氧机虽然体型相对小巧,但是扶手高度过低,导致移动时需要弯腰低伏,长距离推动很容易腰酸背痛。欧姆龙与氧精灵制氧机的离地间隙是五款制氧机中最低的,过门槛时可能出现托底的现象。体积最大重量最重的氧精灵制氧机,它并没有设计方便推动的把手,在机身两侧设计的内凹扣手,不管是推拉还是抬起,都相对较为困难,再结合较重的质量,这都会让中老年朋友的使用稍显困难。

在操作交互方面,海尔ZY5TW制氧机采用全触控操作方式,全中文的按键相比物理旋钮更为直观,氧精灵与鱼跃两款制氧机采用触控加旋钮的操作方式,使用也同样十分方便,而欧姆龙与飞利浦则仅拥有电源开关与物理氧气流量旋钮,流量展示方式也并不是很清晰。这无疑会给老年人的使用带来一丝困扰。
一台适合老人使用的制氧机,一定是能够让他们看得清晰,听得清楚,操作足够方便。即便是眼花耳背的老年人也能够轻松使用。在这一点上,海尔ZY5TW的表现无疑是相对比较好的 无论是全触控的按键操作、液晶流量时间显示,还是大音量语音提示,都非常适合中老年朋友进行使用。

最后我们将重量、移动便捷度和操作便捷度汇总为表格并为五款制氧机打分,方便大家观看
02 配件丰富度
配件丰富度决定着制氧机能够覆盖多少日常使用场景,通常情况下病患在使用制氧机时会采用鼻氧管吸氧的方式进行治疗,但鼻氧管需要插入鼻孔并绕耳佩戴,使用较为不便。如果制氧机配置了类如耳麦式吸氧器、吸氧面罩等配件,就能极大扩充制氧机的使用场景,病患也能获得更好的体验。

我们将所有制氧机赠送的配件汇总后发现,表现最好的依旧是是海尔制氧机ZY5TW,这款制氧机赠送的配件非常丰富,它拥有双人鼻氧管吸氧、耳麦吸氧、面罩吸氧、药液雾化器等等配件,使用场景十分丰富,其次是鱼跃、欧姆龙和氧精灵,拥有鼻氧管与雾化设备,而售价高达5000元的飞利浦反而仅仅赠送一根鼻氧管,机器上也没有专用的雾化杯接口,实际使用场景大大受限。

03 噪音与辐射测试
制氧机属于频繁操作使用的电器设备,机器自身的结构和性能决定了其在运行时会发出一定的声音。如果声音过大,就会影响使用者的氧疗体验,甚至可能会干扰睡眠。
所以在噪音测试时,我们把每台设备置于家庭场景客厅内,并将分贝仪放在距离设备20cm处,在每款制氧机的最高流量设置下,记录设备开启后的噪音数值。
同时,为了解决广大中老年用户的担心,我们也使用辐射检测仪测试了制氧机在工作状态的电磁辐射值

综合来看氧精灵与海尔制氧机的降噪能力相对优秀,运行时的噪音都被抑制在了58分贝以下,处于第二梯队的是飞利浦与欧姆龙,鱼跃制氧机在这项实验的表现相对较差,噪音达到了62分贝以上。
电磁辐射方面,欧姆龙制氧机的辐射值是最高的,磁感应强度达到了8.87微特斯拉,而海尔制氧机则获得了0.227微特斯拉的好成绩。(国标电磁环境控制限值,针对频率范围是50Hz的交流电,电场强度小于4000V/m,磁感应强度小于100μT)

04 制氧能力测试
初中时候我们就学过氧气具有助燃效果。碳在氧气中点燃生成二氧化碳;铁在氧气中点燃生成四氧化三铁。接下来的测试中,我们就运用这些简单的化学知识,测试每一台制氧机的制氧能力。

首先是木条燃烧实验,我们将相同的木条使用喷枪加热到充分燃烧,然后把带火星木条的火焰熄灭,并放置在制氧机出气口,来观察木条复燃情况。

从结果来看,除了欧姆龙外,其余几款制氧机都能轻松将木条吹燃,在点燃状态下继续供给氧气,还能把木条吹得更亮。那欧姆龙制氧机没有让木条复燃,原因应该是制氧机在刚开机状态下氧气浓度提升较慢,实验过程中没有达到让木条复燃的氧气浓度需求。

其次是铁丝燃烧实验,我们把相同的五根铁丝绑上火柴,并使用喷枪点燃,再将其置入集满氧气的集气瓶当中,对比铁丝燃烧速度和亮度,进而得出不同制氧机制出氧气的浓度区别。

从结果可以看出,五款制氧机都可以让铁丝剧烈燃烧,铁丝融化为铁水后滴落到瓶底后,甚至可以让瓶底的玻璃融化,说明五款制氧机所制出的氧气浓度都达到了70%以上。当然这项实验是非常危险的,大家千万不要在家中模仿。

最后是蜡烛水下燃烧试验,我们把蜡烛放置在水面点燃,并用集满氧气的水杯倒扣在蜡烛上,氧气被消耗以后液面便会上升,在这项测试中,液面高度越高,说明制氧机性能越强

从结果来看,在这项实验中海尔制氧机的表现相对出色,液面最终停留在了4厘米以上,其次是欧姆龙和飞利浦,液面刚好停留在了4厘米,鱼跃和氧精灵则在4厘米以下。当然五款制氧机的成绩都十分接近,并且与蜡烛在空气中燃烧的对照组有着不小的区别。
当然 上面3个趣味实验显然是不够严谨的,我们为了得到足够精准的量化参数,分别使用超声波测氧仪检测每台制氧机出气口氧气浓度与流量

结果来看,除了氧精灵稍显虚标以外,其余4款机器都能超额完成目标,欧姆龙、海尔和鱼跃的氧浓度值甚至能达到97%以上。
药液雾化也是制氧机十分重要的一项功能 市场上大多数制氧机都只有单一的制氧功能,而同时进行制氧和雾化又是不少患者的需求。雾化功能便能够更好地针对老人小孩的呼吸系统疾病,将吸入类药物雾化后,可以让身体更好地吸收,同时也免去到医院排队的困扰。

想要测试每台制氧机的雾化能力,需要使用专业的粒径分析仪进行测试,但目前由于疫情管控和雾化液体样本难以保留等原因,我们只能采用另一款不是那么严谨的测试方法:那具体试验方法是在制氧机的雾化组件中加入8毫升食用色素混合液,并快速喷涂在载玻片上,最后使用显微镜观察并测量雾化液滴大小。

在这项实验中,雾化液滴残留痕迹越小、雾化杯中液体越少,说明制氧机的雾化能力越强。从实验结果来看,海尔制氧机喷出的色素液体痕迹是最小的,大家可以对比一下显微镜下的液滴痕迹。飞利浦制氧机由于不具备雾化功能,所以并没有参加这项测试。
05 长期运行稳定性测试
一台好的制氧机,一定是要有稳定、高效的供氧系统。毫无疑问,能够长时间开机运行并且保证氧浓度的稳定性也是考验制氧机性能的关键点。最后一项测试我们将实验5款机器的长期运行稳定性。我们将5组置于培养皿的好氧黏菌放置在富氧环境中,在制氧机连续运行3日后,观察每组黏菌的生长情况。根据黏菌生长情况判断五款制氧机的长期运行氧气浓度和制氧情况。
从延时摄影结果上来看,在富氧环境下生长的黏菌相比正常氧气浓度下的对照组,生长情况确实更为活跃,使用海尔、氧精灵和飞利浦制氧机培养的黏菌生长面积更大,说明这三款机器在72小时的制氧工作中,始终能保持平稳运行。
06 结论
综合所有实验结果,在这次的5款制氧机横评当中,海尔ZY-5TW的成绩表现相对突出,这款机器不仅拥有方便操作的外观设计,制氧浓度、长时间运行稳定性和配件丰富度都是可圈可点。同时,噪音抑制和辐射抑制能力也十分出色。
鱼跃8F-5AW与欧姆龙KJR-Y53W两款制氧机体型小巧,制氧量和氧气浓度表现也相对优秀,不过鱼跃制氧机的噪音略大,超过了62分贝,欧姆龙制氧机在开机时的氧气提升速度较慢,配件丰富度也不及海尔制氧机。
氧精灵KJR-Y59W体积和重量较大,推拉抬起都需要一些力气,在氧气浓度和流量测试中,也略显逊色,甚至没有达到95%的氧气浓度标准。
最后是飞利浦Everflo,虽然制氧效果出色,但缺少雾化功能和定时功能,流量调节也不够直观。
综合售价考量,海尔ZY-5TW是性价比比较高的,相信这款配件功能丰富,降噪与防辐射设计出色,雾化细腻,且能够长时间制氧的制氧机,能够轻松服务呼吸系统疾病患者。而氧精灵与飞利浦的制氧机就不是很推荐了,前者过于笨重影响操作,后者功能单一价格过高。
很多的消费者会认为国外的品牌比较好,实际上目前中国制造已经达到了较高的水准。从这次横评当中大家也能看出,售价最高的外国品牌已经被众多国内品牌超越。得益于我国在资金、人才、技术等领域数十年的积累,中国自主品牌在磨砺中不断进步,在医疗健康领域,也必将更好的维护好国人的健康。